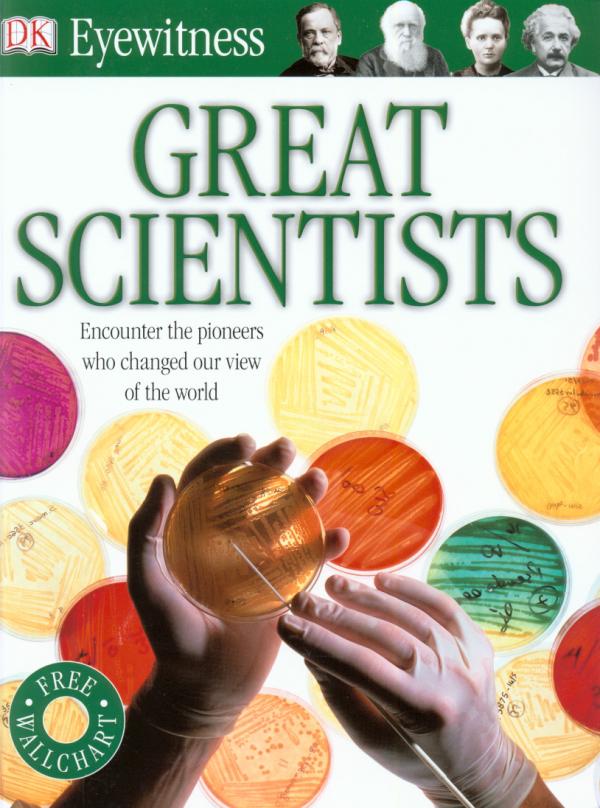

Eyewitness Great Scientists
Состояние:
Полное описание:
Это увлекательный и информативный путеводитель по увлекательной жизни самых известных мыслителей, философов, изобретателей, новаторов и первопроходцев мира. Потрясающие фотографии предлагают уникальный взгляд на идеи и инновации, которые изменили наш образ жизни сегодня.
Ваш ребенок узнает все об электрических зарядах Бенджамина Франклина, теории относительности Альберта Эйнштейна и многих других, чьи открытия сформировали наш мир. Энциклопедия также включает в себя гигантскую раскладную настенную таблицу с фактами, которая идеально подходит для спален или классных комнат.
Переплет:
Мягкий
Состояние:
Новая
Издательство:
ISBN:
9781405373234
Язык:
Английский
Количество страниц:
72
Габариты позиции:
214 x 281 x 7
Вес:
400
Нет в наличии
Количество позиций в наличии:
0
Хиты продаж
Little Golden Book: Mommy Stories (3 books in 1)
Небольшой дефект на форзаце
Maisy Grows a Garden Pull The Tabs and Let's Get Growing!
Залом на уголке
Lift-the-Flap First Questions and Answers What is a Virus?
На обложке дефект